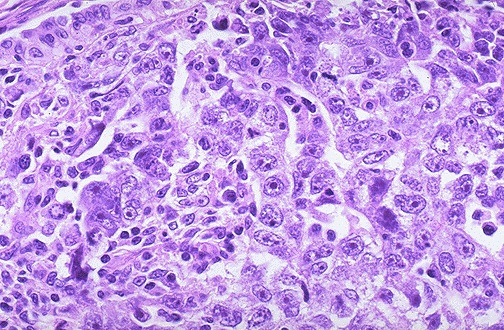

| This neoplasm is so poorly differentiated that it is difficult to tell what the cell of origin is. It is probably a carcinoma because of the polygonal nature of the cells. Note that nucleoli are numerous and large in this neoplasm. Neoplasms with no differentiation are said to be anaplastic. |
![]() |